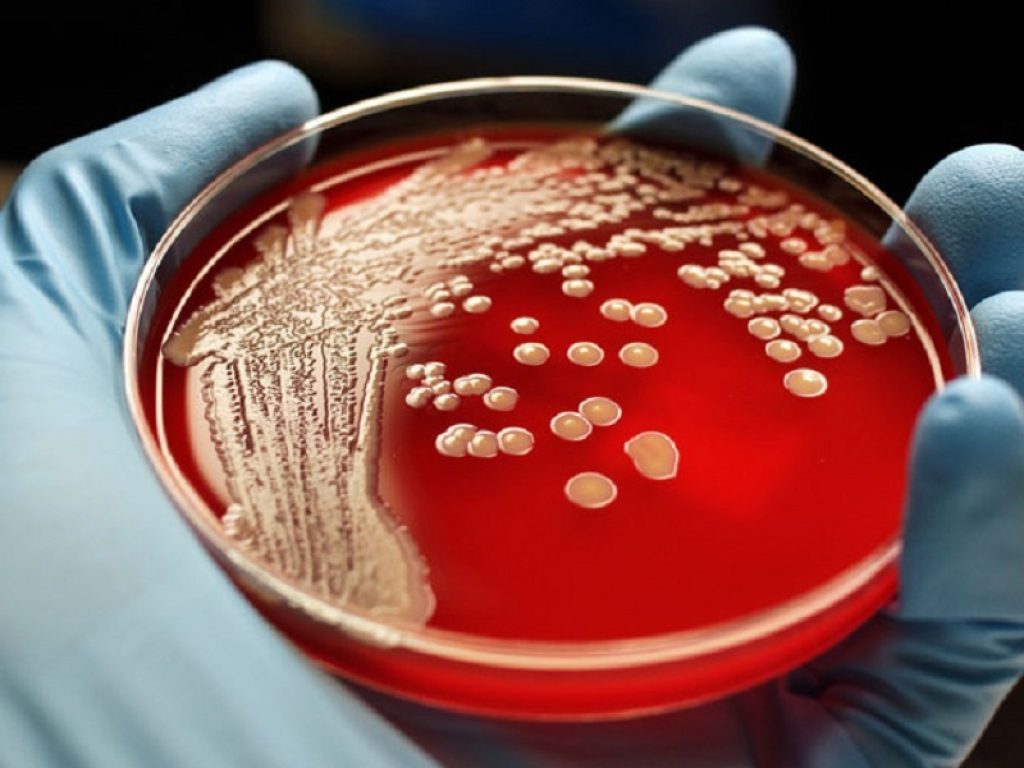

Un gruppo di ricerca internazionale ha ideato una terapia basata su CRISPR – per ora sperimentata su modello animale – che mira a colpire il batterio E. coli
Le infezioni da Escherichia coli sono un inconveniente spiacevole per chiunque ma, in particolare, per le persone affette da un tumore del sangue, per le quali può rivelarsi anche fatale. Questo accade quando il batterio, naturalmente presente nell’intestino, si riversa nel flusso sanguigno e il sistema immunitario non riesce a contrastare la sua presenza, causando una infezione che ha un tasso di mortalità del 15-20%. Gli antibiotici sono i farmaci standard in questi casi, ma hanno effetti collaterali da non sottovalutare – tra cui i danni al microbioma – e il loro utilizzo è sempre più complesso a causa dei fenomeni di antibiotico-resistenza. Proprio per questo, un team internazionale ha messo a punto il primo candidato a base di CRISPR che ha lo scopo di colpire direttamente E. coli, lasciando intatto il microbioma. Lo studio è stato pubblicato a maggio su Nature Biotechnology.
Il microbioma – ossia l’insieme di microrganismi che convivono con l’organismo umano – svolge un ruolo cruciale per il nostro benessere e gli antibiotici possono danneggiarlo mentre esplicano la propria naturale funzione. A questo si aggiungono i crescenti problemi legati alla resistenza antibiotica, che rendono gli antibiotici meno efficaci nel curare le infezioni: basti pensare che nel 2019 è stato stimato che quasi 1,3milioni di decessi siano stati attribuibili al fenomeno della resistenza, con E. coli come principale protagonista (25-30% del totale e fino al 65% nel caso di persone con tumori ematologici).
Nel caso di persone affette da tumori del sangue, il rischio che E. coli si diffonda nel sangue e causi una infezione sistemica è più alto, anche a causa delle terapie a cui devono sottoporsi per la gestione della malattia. Il trattamento sopprime la produzione di cellule del sangue da parte del midollo osseo del paziente e provoca un’infiammazione intestinale. L’infiammazione aumenta la permeabilità dell’intestino, consentendo ai batteri intestinali di entrare nel flusso sanguigno e rendendo il paziente vulnerabile.
Sebbene in questi casi estremi vangano utilizzati i fluorochinoloni – ultima scelta quando non funzionano gli antibiotici più comuni, ma che ha molti effetti collaterali – molti ceppi batterici hanno sviluppato delle resistenze che non vengono sconfitte da alcun antibiotico, con inevitabili conseguenze. Proprio per questo motivo, un gruppo di ricerca internazionale – che ha visto la collaborazione della Technical University of Denmark (Danimarca), JAFRAL (Slovenia), JMI Laboratories (Stati Uniti) e la Divisione di Malattie Infettive della Weill Cornell Medicine (Stati Uniti) – ha ingegnerizzato 4 virus che attaccano specificatamente i batteri (chiamati ‘fagi’), con l’obiettivo di eliminare solo E. coli lasciando intatto il microbioma. La tecnica protagonista di questo innovativo approccio contro le infezioni e l’antibiotico-resistenza è CRISPR: un sistema di editing genomico che ha origine nei batteri, utilizzato contro i batteri stessi (ne avevamo già parlato qui e qui).
Lo studio è partito analizzando una ‘libreria’ di 162 fagi, da cui ne sono stati individuati 8 in grado di colpire E. coli: CRISPR è stata poi utilizzata per migliorare le potenzialità dei fagi selezionati. È stato scoperto che una combinazione di 4 di questi fagi – ‘cocktail’ che hanno chiamato SNIPR001 – ha una maggiore efficacia rispetto ai fagi non modificati e ha ridotto la quantità di E. coli. Inoltre, dal punto di vista degli effetti collaterali, è stato ben tollerato nei modelli animali.
I fagi vengono ingegnerizzati e armati con sistemi Crispr-Cas contenenti sequenze specifiche per l’E. coli, creando i cosiddetti CAP (Cas-armed phages, fagi armati di Cas). In poche parole, la terapia sperimentale SNIPR001 comprende quattro CAP complementari e si dovrebbe comportare come un antibiotico di precisione che colpisce selettivamente l’E.coli per prevenire la batteriemia nei pazienti affetti da tumori ematologici a rischio di neutropenia (bassi livelli di globuli bianchi). In questi casi è prevista la somministrazione preventiva di antibiotici prima della chemioterapia, ma lo studio di soluzioni alternative e più efficaci prosegue e i fagi sono un obiettivo di grande interesse per la ricerca.
SNIPR001 è attualmente in fase iniziale di sviluppo, ma ha già ottenuto la Fast Track Designation – cioè il processo di revisione accelerata – da parte della Food and Drug Administration (FDA) statunitense. Sempre negli Stati Uniti è attualmente in corso uno studio clinico di Fase I per valutare la capacità di SNIPR001 di accertare la sicurezza e la sua capacità di ridurre l’E. coli nell’intestino senza perturbare il microbioma intestinale complessivo.
Sono però ancora pochi gli studi clinici sulla loro efficacia in questo ambito e i risultati non sono di certo conclusivi, ma è importante percorrere nuovi sentieri di ricerca. CRISPR, che negli anni è stata spesso associata al termine rivoluzione, potrebbe quindi rivoluzionare anche la gestione delle resistenze antimicrobiche tramite la messa a punto di una cosiddetta terapia fagica. Identificare e isolare fagi in grado di uccidere un ceppo batterico, modificarli e potenziarli in laboratorio e usarli per contrastare le infezioni: un antibiotico di precisione a tutti gli effetti.